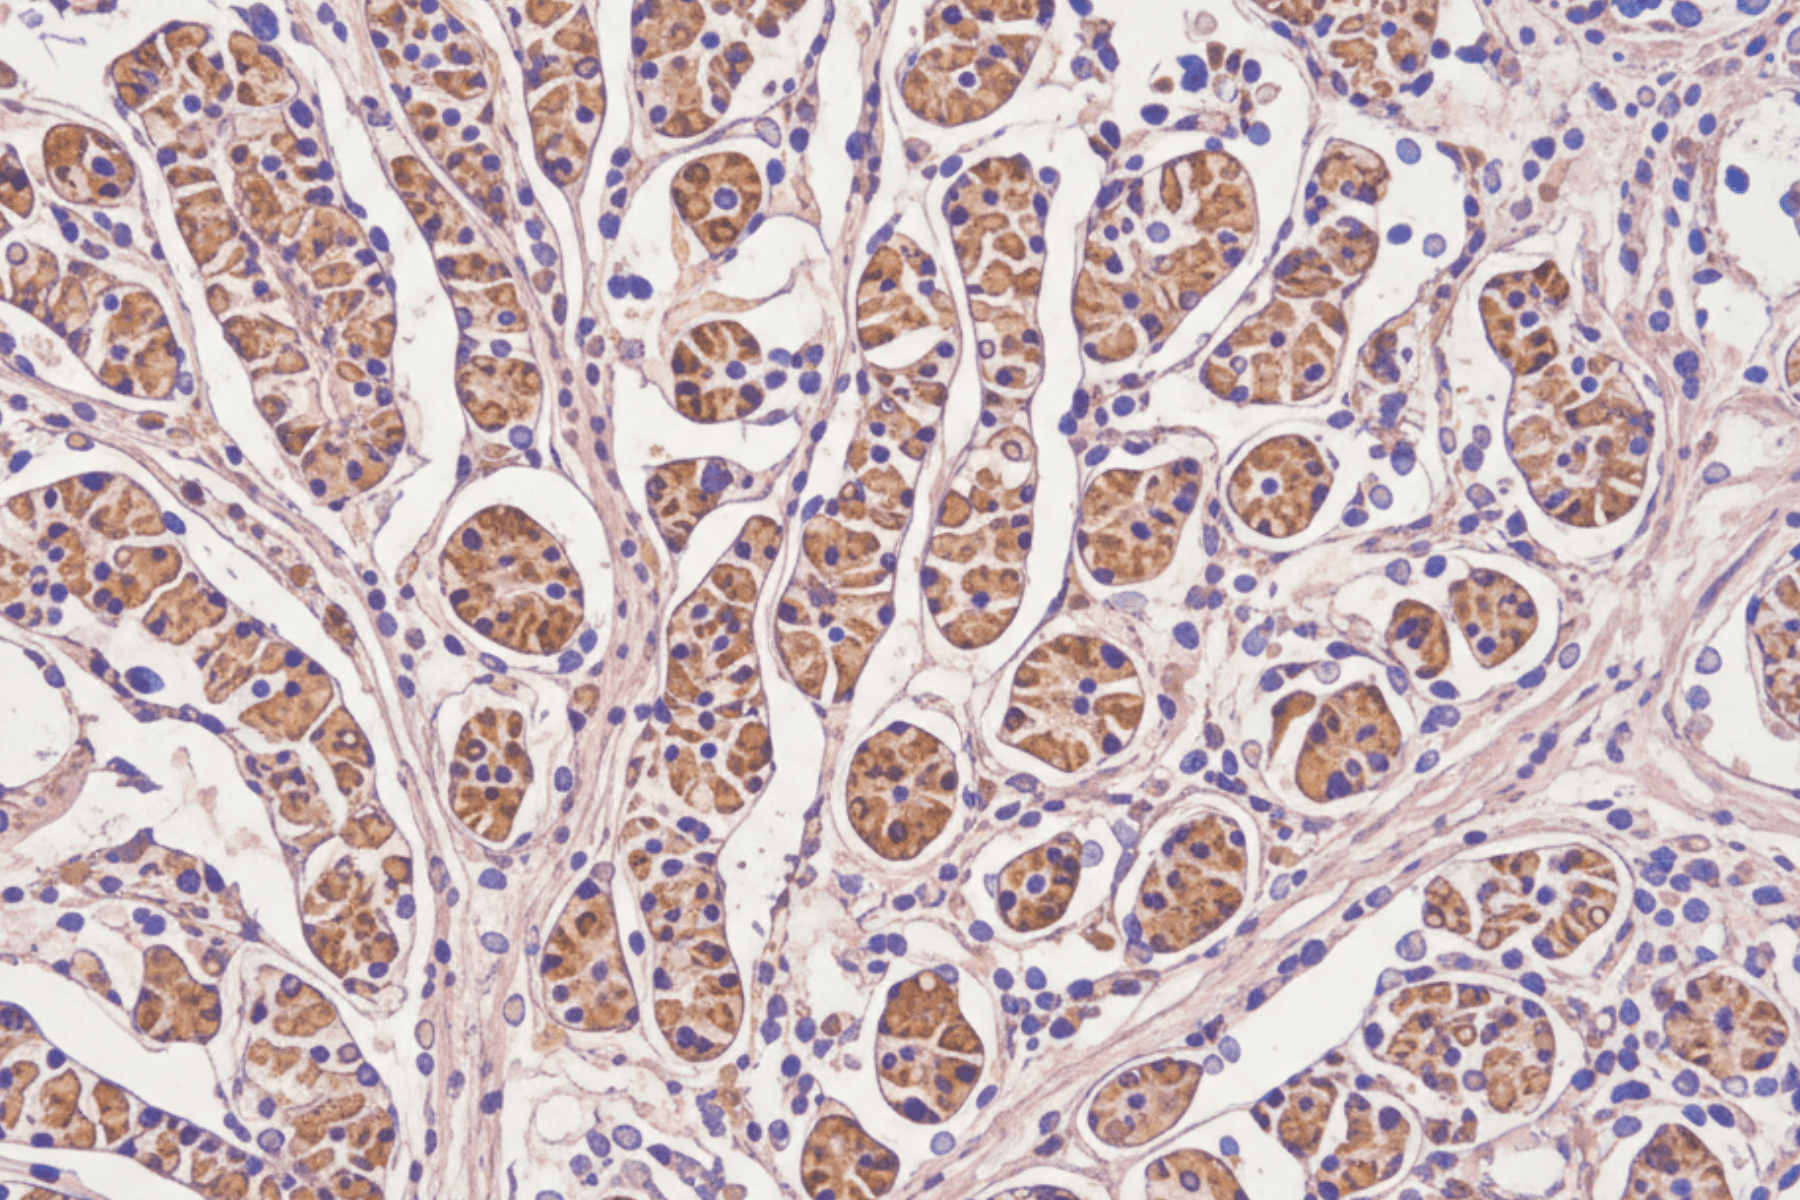

Our Scientific Solutions
Cancer On Chip

Speed up the discovery of innovative immunotherapies and reveal key mechanisms within the tumor microenvironment
Cancer on chip is a more accurate and efficient approach for studying the mechanisms behind cancer growth and progression. This cutting-edge technology provides a potent platform for investigating the complex interactions between cancer cells and their microenvironment in a controlled environment.
With our innovative Cancer on Chip precision and accuracy are improved, leading to accelerated drug discovery timelines and improved outcomes.

3D-flowGel
Super-fast, highly flexible, and reproducible, it’s a ready to use 3D cell culture hydrogel that closely resembles the extracellular matrix (ECM).
Easily move to 3D cell culture
Permissive to chemical functionalizations, stable over time, and mechanically tunable, 3D-flowGel allows optimization of the in vitro cell culture in a 3D fashion, encouraging long-term cell viability, selective migration, and protein secretion. Due to its chemical composition, 3D-flowGel supports an extensive spectrum of downstream analysis through an easy and fast cell recovery.
Moreover, 3D-flowGel recapitulates the in vivo tissue barrier conditions for more predictive diffusion of molecules, nanoparticles and drugs under testing.
Cancer-on-Chip Readouts
A more realistic and physiologically relevant environment for more predictive readouts
Cancer Cells Phenotype Characterization
Utilizing state-of-the-art flow cytometry, our platform offers comprehensive phenotype characterization of cancer cells, providing detailed insights into surface marker expression, cell cycle status, and apoptosis on specific cancer cell populations (i.e. circulating cancer cells, infiltrated cells)
Drug Efficacy
With a cancer on chip we measure key parameters such as cell viability and apoptosis to determine the effectiveness of new compounds like chemotherapeutic agents, targeted therapies, and immunomodulating agents. By leveraging advanced techniques, we evaluate how different drug classes impact cancer cells, providing critical data to support the development of next-generation cancer treatments.
Immune Cells Infiltration
Our platform enables the detailed analysis of immune responses, including the infiltration of T cells, NK cells, and macrophages, as well as the activation status of these immune cells. By simulating the interaction between cancer cells and the immune system, we provide critical insights into the efficacy of immunotherapies, checkpoint inhibitors, and other immune-modulating treatments.
Cancer on Chip References
Demichelis MP et al, ACS Nano 2025 – Coupling Adoptive Cell Therapy with Boron Neutron Capture Therapy: Using Functional Tumor-Infiltrating Lymphocytes for Tumor Delivery of Boron Carbide Nanoparticles
Argenzano M. et al, International Journal of Pharmaceutics 2025 – Gemcitabine-loaded ICOS-Fc decorated nanosponges: A new chemo immunotherapy combination against pancreatic cancer
Parodi I. et al, Gels 2025 – Core-Shell Hydrogels with Tunable Stiffness for Breast Cancer Tissue Modelling in an Organ-on-Chip System
Tien T.T. Truong et al, Engineered Regeneration 2025 – Integrating bioprinted oral epithelium with millifluidics to bioengineer oral mucositis-on-a-chip
Fedi et al, Bioengineering 2023 – A Human Ovarian Tumor & Liver Organ-on-Chip for Simultaneous and More Predictive Toxo-Efficacy Assays
Tumor Angiogenesis Assays, Methods and Protocols, Methods in Molecular Biology – 3D Human Tumor Tissues Cultured in Dynamic Conditions
as Alternative In Vitro Disease Models – Chapter 16
Parodi et al, Gels 2023 – 3D Bioprinting as a Powerful Technique for Recreating the Tumor Microenvironment
Marzagalli M et al, Front. Bioeng. Biotechnol. 2022 – A multi-organ-on-chip to recapitulate the infiltration and the cytotoxic activity of circulating NK cells in 3D matrix-based tumor model
Fiore et al, Cancer Immunol Immunother. 2022 – Different effects of NK cells and NK-derived soluble factors on cell lines derived from primary or metastatic pancreatic cancers.
Vitale C et al, Cancers 2022 – Tumor Microenvironment and Hydrogel-Based 3D Cancer Models for In Vitro Testing Immunotherapies
Zimmer J et al, Frontiers in Immunology 2021 – Recent 3D Tumor Models for Testing Immune-Mediated Therapies
Marrella A et al, Altex 2020 – 3D fluid-dynamic ovarian cancer model resembling systemic drug administration for efficacy assay
Marrella A et al, Front. Immunology 2019 – Cell-Laden Hydrogel as a Clinical-Relevant 3D Model for Analyzing Neuroblastoma Growth, Immunophenotype, and Susceptibility to Therapies
Cavo M et al, Sci Rep. 2018 – A new cell-laden 3D Alginate-Matrigel hydrogel resembles human breast cancer cell malignant morphology, spread and invasion capability observed “in vivo”
Get a Quote
We are here for you
Whether you’re looking for a quote or want to connect with us, fill out the form below with your details, and we will be in touch shortly.
All fields are required, take your time.